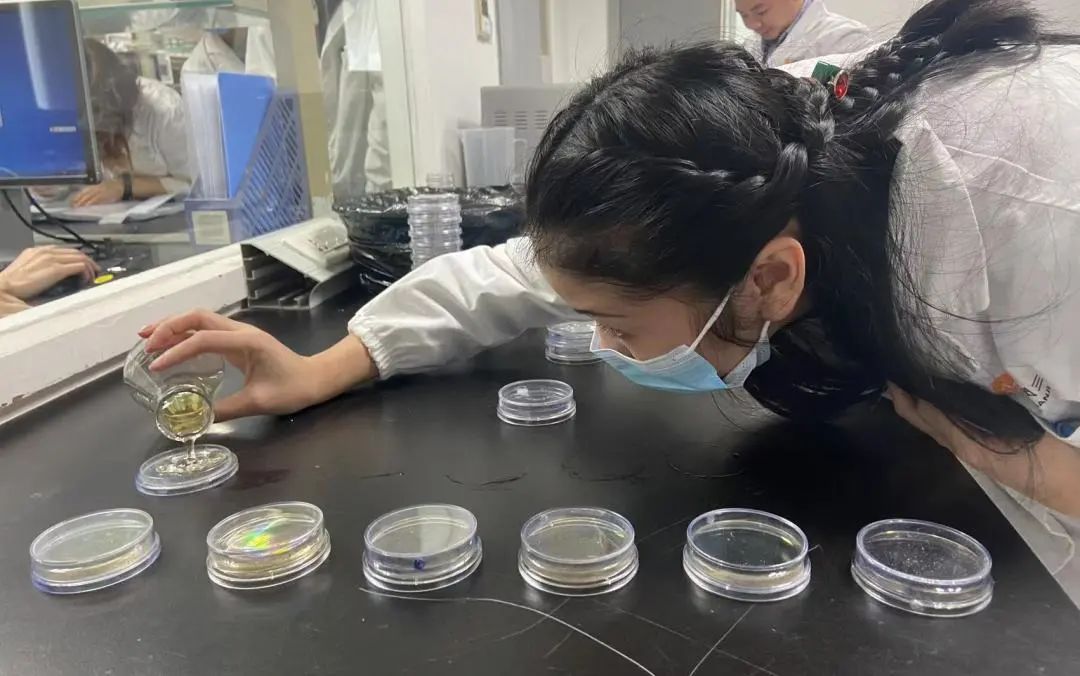

来源 :华润三九2021-12-30
12月22日至23日,“2021广东企业思想建设与企业文化建设工作年会”在珠海召开。会议聚焦“党建引领.文化铸魂”这一主题,深入总结广东企业党建与企业文化建设先进经验,共同探索广东企业党建引领企业文化建设的创新举措;表彰一批在企业思想政治工作与企业文化建设方面起到典型示范作用的先进组织和个人。其中,华润三九荣获2021年度“广东省企业文化建设最佳实践单位”。

中央党校原副校长徐伟新,中央政府驻澳门特别行政区联络办公室原副主任、中国侨联原副主席李本钧,广东省人民政府原副秘书长,广东文史学会会长江海燕等以及来自全省的企业家、企业党务工作者及企业文化建设工作者、新闻界代表等100多人与会。
本次大会是在习近平新时代中国特色社会主义思想指引下,深入学习贯彻落实党的十九届六中全会精神和习近平总书记关于文化建设的系列重要论述,继承发扬伟大建党精神,赓续红色血脉。通过交流探讨“以党建引领企业文化建设”的先进经验和做法,进一步明确新时代企业文化发展方向,加强企业党务工作者与企业文化人才队伍建设,推动企业高质量发展。

持续推进质量宣传月项目
作为国内领先的医药健康行业上市公司,华润三九始终坚守制药人的价值观和责任感,并融入企业文化建设全过程。一是将质量文化与企业文化工作相融相合,大力倡导主人翁意识,让员工在质量提升中自觉发挥监督作用;二是持续开展系列主题文化活动,让“质量意识、质量管理、质量提升深入人心”。

自2008年以来,华润三九持续推进“平凡岗位也美丽?质量宣传月”项目,至今已连续举办了13届,项目组围绕质量管理要求,组织策划的“岗位技能大赛”、“知识竞赛”等经典活动,和一系列优秀创新活动如“质量圣火传播”、“开放空间”、“辩论赛”、“质量交流会”等,持续不断地提升全体员工的质量意识,将质量意识内化于心、外化于行。为生产优质产品、打造卓越质量管理体系保驾护航。